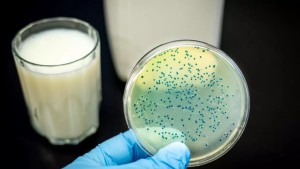
Brusella Hastalığı Nedir?

Hastalıklar kategorisi, geniş bir yelpazede sağlık sorunlarını ele alan içerikleri içermektedir. Bu kategoride, çeşitli hastalıkların tanımları, belirtileri, nedenleri ve tedavi seçenekleri hakkında kapsamlı bilgiler bulunmaktadır. Ayrıca, önleyici tedbirler ve sağlıklı yaşam alışkanlıkları konularında bilgilendirici içerikler de bu kategori içerisinde yer almaktadır.
Hastalıkların genel etkileri, bireylerin yaşamlarını nasıl etkileyebileceği ve toplum sağlığı üzerindeki potansiyel etkileri gibi konulara odaklanan içerikler, okuyuculara hastalıkların ciddiyeti konusunda bilgi sağlamayı amaçlar. Bu makaleler, belirli hastalıklara özgü bilgilerin yanı sıra genel sağlık prensipleri, sağlıklı beslenme ve egzersiz gibi konuları da kapsayarak okuyuculara sağlıklı yaşam konusunda rehberlik etmeyi hedefler.
Hastalıklar kategorisi, okuyuculara belirli sağlık durumları hakkında derinlemesine bilgi sunmanın yanı sıra, sağlıkla ilgili genel farkındalığı artırmak ve bireyleri sağlıklı yaşam konusunda motive etmek amacıyla çeşitli konuları ele alır. Bu içerikler, hem bireylerin hem de toplumların sağlık konularında bilinçlenmelerine katkıda bulunmayı hedefler.